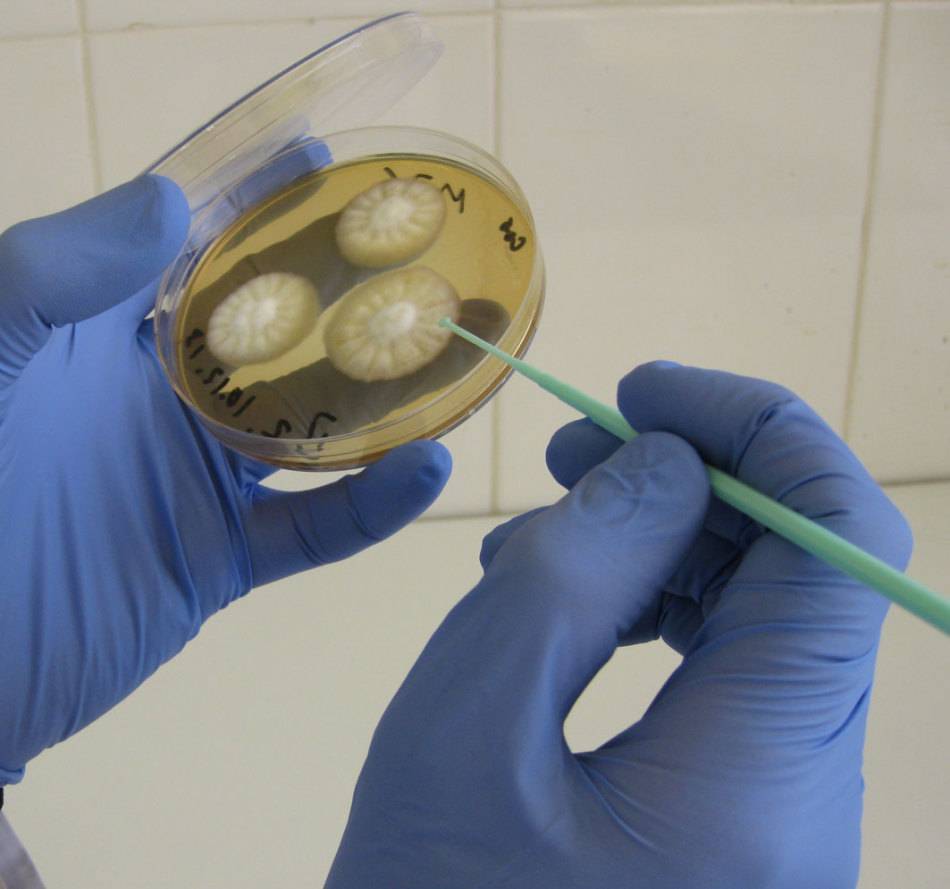

Симптомы
Заподозрить демодекоз у собаки можно по следующим симптомам:
- потеря аппетита;
- изменения кожного покрова — сильное выпадение шерсти, сухость, покраснение;
- общее угнетенное состояние.
Для чешуйчатой формы:
- образование на морде безволосых островков;
- на коже в больших количествах можно заметить сухие сероватые чешуйки;
- на поздних стадиях кожа становится анемичной (бледной) и даже приобретает синеватый оттенок.
Для пустулезной формы:
- на коже видны явные признаки воспаления — она покрасневшая, опухшая, морщинистая, даже напоминает целлюлит;
- четко прощупываются узелки под кожей;
- со временем пустулы (узелки) вскрываются и из них выходит гной, он чаще желтого цвета, но может быть и темным;
- образуются незаживающие ранки — язвы;
- от собаки исходит явно неприятный запах;
- характерно увеличение поверхностных лимфатических узлов.
1.Что такое демодекоз и провоцирующие его факторы?
Демодекоз (демодекс, кожный клещ) микроскопический клещ Demodex folliculorum, заселяющий сальные железы кожи и волосяные фолликулы век. Этот паразит чаще всего является причиной проблемной кожи лица и прыщей на теле (спина, грудь, плечи).
Клещ обитает повсеместно, и рано или поздно попадает на кожу любого человека. Однако, заселяется и начинает активно размножаться лишь при определенных условиях:
- повышенная жирность кожи;
- ослабленный иммунитет;
- нарушения обмена веществ;
- нарушения образа жизни, гигиены;
- хронические заболевания, снижающие защитные свойства кожи;
- постоянные стрессогенные факторы.
Паразит Demodex folliculorum имеет продолговатую форму, он почти прозрачен, размер взрослой особи 0,1 – 0,4 мм. Различить его без специальной аппаратуры невозможно. Питается клещ клетками кожи и кожным салом. Живёт паразит всего несколько дней. Особь устроена так, что у неё нет органов выделения. В течение жизни клещ только питается и производит потомство. Затем погибает. Развитие личинки из яйца также занимает 2-3 дня. Таким образом, можно предположить, что интенсивное лечение уничтожает всех взрослых паразитов и отложенных ими личинок за неделю. Однако, на практике всё не так просто. Хроническое течение демодекоза обусловлено постоянным перезаражением человека от собственных же бытовых предметов. Особенно много личинок кожного клеща на полотенцах, наволочках, расческах и массажных щетках для волос, косметике.
Лечение болезни
Опять же, существует как минимум две точки зрения о возможности полного выздоровления домашнего питомца:
- Первый – пессимистичный.
- Второй – оптимистичный.
Лечение, конечно же, комплексное и состоит из нескольких видов лекарств разной направленности. Если к демодекозу прибавляется бактериальная инфекция, то в 90 процентах случаев больной собаке назначают антибиотики. Помимо этого, применяется местная обработка. Также для поддержания работы печени используют инъекции ивомек и аналогичные препараты.
Внимание, аналоги должны быть без витаминов! Чтобы укрепить иммунитет, питомцу назначают иммуностимуляторы. Очень важна в период лечения диета с низким содержанием витаминов группы B и белка
Хозяин должен обеспечить также комфортные условия пребывания для собаки – это обязательно сухое помещение, без сквозняков и влаги. Это может негативно сказаться на лечении и вызвать рецидив.
После курса лечения профилактику продолжайте еще две недели после полного исчезновения симптомов подкожных клещей.
Как выглядит демодекоз
Таким образом, питомец считается здоровым, если за восемь месяцев после болезни не произошло ни одного повторения. Соскоб эпителия сдают трижды. Анализ в трех случаях должен показать отрицательный результат. Помимо этого, ветеринары советуют сдать анализ биохимии крови или мочи, для определения общего состояния собаки.
Необходимо это, так как лечение происходит при использовании сильных медикаментов, воздействующих на печень и другие внутренние органы.
Наглядный пример. До и после лечения.
Лечение демодекоза у собак длительный и, скажем откровенно, дорогостоящий процесс. Поэтому следует помнить о том, что лучшее лечение – это профилактика. Заботьтесь о здоровье питомца уже сегодня.
Если видите первые признаки болезни, не тяните и скорее бегите в, проверенную ветеринарную клинику. Ведь упущенное время негативно скажется на здоровье собаки. И даже привести к летальному исходу.
Лечение демодекоза у собаки
При подтверждении диагноза, ветеринар приступает к разработке тактики лечения. Она зависит не только от степени повреждения кожи животного, но и от общего состояния организма собаки. Полное излечение возможно только при комплексном подходе. Ветеринары назначают несколько видов препаратов, имеющих различную направленность. Сложность терапии заключается в том, что одни лекарственные средства могут проникать в кожный покров и уничтожать только половозрелых особей паразитов, другие же напротив, провоцируют гибель исключительно личинок, располагающихся под верхним слоем эпидермиса, питаясь тканевой жидкостью и отмершими частичками кожи.
Лечение в ветеринарной клинике
При своевременном обращении в ветеринарную клинику, собак, больных демодекозом, лечат амбулаторно
Важно, чтобы владелец придерживался схемы лечения, прописанной врачом. Если же обращение в клинику произошло на поздних этапах патологии, сопровождающейся сепсисом, болезненными ощущениями, лихорадочными состояниями, пиодермия, дегидратацией организма, специалисты рекомендуют госпитализацию животного
В условиях стационара, собаке смогут предоставить надлежащий уход и лечение для поддержания всех функций организма. Возможно, потребуется введение специальных раствором, антибиотиков и обезболивающих средств.
При диагностированном демодекозе у пациента, назначаются не только препараты, основная цель которых – уничтожению паразитов, но и лекарственных средств, устраняющих признаки интоксикации организма, препаратов для повышения защитных сил организма и регенерационных свойств кожи. Наличие секундарной микрофлоры означает, что потребуется введение антибиотиков или антимикотических препаратов.
Уничтожение самих паразитов под кожей, осуществляется путем назначения таких лекарственных препаратов, как:
- Ивермектин – уничтожает личинки и яйца паразитов. Собакам с сильно ослабленным иммунитетом, Ивермектин назначают редко. Также не рекомендуется введение сильнодействующего препарата маленьким щенкам и беременным сукам.
- Бравекто – уничтожает половозрелых микроскопических клещей начиная с первых часов воздействия.
- Серная мазь – противовоспалительное средство, оказывающие выраженный противомикробный эффект и уничтожает взрослых особей клеща, а также их личинки. Мазью обрабатывают наружные кожные покровы.
Заниматься самолечением при подозрении на демодекоз у собаки, не только не эффективно, но и опасно для жизни животного.
Запущенные случаи патологического процесса, не просто приводят к болям у питомца, но и способны стать причиной серьезных осложнений во всем организме.
Лечение демодекоза у собаки в домашних условиях
При легких формах демодекоза, лечение осуществляется в домашних условиях. Амбулаторное лечение проводиться исключительно под четким контролем врача. Только врач может посоветовать антибиотики для борьбы с секундарной микрофлорой и противогрибковые средства. Специалист должен проконсультировать владельца по поводу использования шампуней для купания, позволяющих восстановить защитный барьер кожи быстрее.
Важная часть домашнего лечения, не только четкое выполнение рекомендаций ветеринара, но и оптимизация питания больного животного. Любимец должен получать максимально сбалансированное по всем нутриентам питание, с учетом возрастных особенностей.
Лечение демодекоза у собак Ивермеком, Бравекто, Мирамистином, Ивермектином, каплями Адвокат: инструкция по применению
Теперь несколько слов об еще одних популярных препаратах для лечения демодекоза:
«Ивермек» — препарат этот заслуженно считается одним из лучших, и при небольшой дозировке внутримышечно производит удивительный эффект. Расчет должен быть следующим – на 5 кг веса собаки нужно ввести 0,1 мл лекарства. Можно развести его стерильным растворителем.

Инвермек ветеринары советуют часто для лечения демодекоза
«Бравекто» — исследования показывают, что подавляющее количество паразитов погибает буквально в первые 12 часов после того, как животное примет таблетку. Съесть ее животное должно либо во время приема пищи, либо в скором времени после этого. На килограмм веса должно приходиться примерно 25-56 г препарата
Знать это важно, так как фасовка таблеток различна, поэтому произвести расчет следует до похода в ветеринарную аптеку.
«Мирамистин» — считается эффективным средством-антисептиком при обработке ранок. Наносится марлевым тампоном дважды или даже трижды в день на протяжении 4-5 дней.
«Адвокат» — на 1 кг веса должно прийтись примерно по 0,1 мл капель
Нужно их наносить строго на неповрежденное тело, предпочтительно в качестве начальной точки стоит выбрать область лопаток. Далее нужно двигаться к хвосту – всего должны получиться 3-4 обработанные зоны. В среднем должно быть 2-4 сеанса лечения. Интервал нужно соблюдать примерно в месяц.

Капли Адвокат для лечения демодекоза
«Ивермектин» — его допустимо как вводить в виде инъекции, так и давать в виде таблетки. В первом случае дозировка следующая – на килограмм веса вводится 0,4 мг лекарства. Во втором же на килограмм веса нужно дать раз в день 0,6 мг препарата.
Пути заражения и как распространяется клещ
Заразиться ваша собака может только при контакте с больным животным, так как в окружающей среде клещ может жить максимум час.
В большинстве случаев заражение происходит в первые три месяца жизни щенка. Чем старше становится питомец, тем сильнее ороговение эпидермиса затрудняет перемещение клеща на животное.
Щенки почти всегда заражаются от матери. Это обусловлено тесным контактом во время кормления. Сигналом к перемещению с одного животного на другое для клеща служит повышение местной температуры, что всегда происходит при контакте собак. Когда они играются или просто обнюхивают друг друга.
Есть предположение, что демодексы живут практически на всех собаках, и при крепком иммунитете животного никак себя не проявляют, иными словами — являются нормой. Это только предположение объясняет многие случаи, когда собаки являются носителями этих клещей, но при этом клинических проявлений болезни нет.
У взрослых особей заболевание развивается в основном на фоне резкого снижения иммунитета, например при:
- гормональных сбоях
- иммунодепрессии
- химиотерапия на фоне онкологии
- аутоиммунные заболевания.
Также существует закономерность, исходя из которой предполагают, что восприимчивость к демодекозу передаётся по наследству. Поэтому больных животных не допускают к разведению.
Что такое демодекоз и кто является возбудителем заболевания
Демодекоз у собак — это паразитарное заболевание, вызванное особой формой чесоточного клеща Demodex Canis, обитающего исключительно на собаках.
Демодекозом могут болеть как животные, так и люди. Но вероятность передачи заболевания человеку от собаки и наоборот исключена. Дело в том, что возбудителем недуга у человека является один вид паразита (Demodex folliculorum), а у собак другой.
Demodex Canis — это мелкий клещ, которого можно рассмотреть только под микроскопом. Взрослые особи достигают всего лишь 0,4 мм в длину. Полупрозрачное вытянутое тельце, короткие лапки и очень мощный (если можно так сказать) для столь микроскопического паразита челюстной аппарат.
Поселяется клещ в волосяных фолликулах животного или в сальных и потовых железах, расположенных около стержня волос. Там для него наилучшие условия. Благодаря чешуйкам, расположенным на теле, он отлично закрепляется в своём «логове». Выедая содержимое волосяного фолликула, взрослый клещ движется к следующему источнику «пищи» прогрызая себе путь и выедая клетки эпителия, доставляя своему «хозяину» массу неприятных ощущений.

Отсюда у животного и характерные признаки заболевания: постоянный зуд и выпадение шерсти. Выгрызенных «туннель» заполняется межклеточной жидкостью, которая отлично благоприятствует появлению бактерий. Вот поэтому заболевание демодекозом нередко дополнительно сопровождается бактериальными инфекциями.
В местах своего обитания взрослые особи откладывают яйца, и уже через месяц из них вырастают зрелые клещи. В одной волосяной фолликуле одновременно может находится целая колония паразитов — до 5 тысяч клещей разной степени развития. Взрослые особи питаются содержимым волосяных фолликул и сальных желез. А личинки поедают погибшие клетки.
Когда паразитов становится очень много, в поисках «пропитания» они прокладывают себе путь всё глубже и глубже. Если вовремя не начать лечение, колонии клещей проникают в печень, почки, лимфатические узлы и другие внутренние органы собаки.
Вот при таких сложных формах демодекоза животное либо уже не поддаётся лечению, либо после длительной и тяжёлой терапии всю оставшуюся жизнь страдает от последствий этого страшного заболевания.

Демодекоз у собак: начальные признаки, симптомы
Итак, каковы же начальные симптомы декомодекоза?
Зуд, причем сильный. Конечно, все животные время от времени чешутся. Однако если это происходит в течение нескольких часов подряд, определенно стоит показать собаку ветеринару.
Если собака часто и длительно чешется, это может быть начальная стадия демодекоза
- Стоит присмотреться к основанию шерстинок – там будут покраснения.
- Через несколько дней на местах подобных покраснений начинают появляться пузырьки. Внутри них имеется содержимое, которое можно разглядеть. Оно по цвету напоминает сначала кирпич, а позже – глину. Так проявляется так называемая гнойничковая форма заболевания.
- В некоторых случаях можно обнаружить сухие чешуйки. Несмотря на то, что они сухие, шерсть рядом словно бы склеивается. Могут напоминать отруби или чешую рыбы.
- Спустя несколько суток после образования чешуек они отпадают. Под ними можно заметить гной.
- В некоторых случаях температура тела животного составляет примерно 37 градусов. К слову, для собак это ненормально, так как оптимальная температура тела у здорового пса – от 37,5 до 39,4 градусов в зависимости от размеров.
- Собака может отказываться от еды, испытывать угнетенное состояние.
Собака при демодекозе часто не имеет аппетита
Причины появления подкожных клещей у собак
Повышенная активность клеща Demodex – вот причина появления подкожного клеща у собаки. Возбудитель болезни настолько маленький, что разглядеть можно только под микроскопом. Разновидностей демодекса много – ученые насчитали 140 видов! Стоит отметить, что от домашних животных, в том числе и от собаки, человек заразиться не может. Также как и не сможет передать «человеческого» клеща питомцу.
На латыни полное название клеща – Demodex Canis. Это маленький паразит вытянутой формы, похожий на червяка. Рот паразита оснащен острыми «зубами». Половозрелый клещ переползает к стволу волоса, освобождает себе путь к фолликулу или сальной железе, прогрызая клетки верхнего слоя кожи.
Демодекоз у собаки появляется не сразу, а тогда, когда образуются большие паразитические колонии. Так, в одной сальной железе или в фолликуле волоса находится две сотни паразитов. Такое количество микроорганизмов образуется из-за размножения клещей и последующего превращения личинок в половозрелую особь. Отметим, что разъедают верхний слой кожи только взрослые клещи, молодые же питаются погибшими клетками.
Паразит под микроскопом
Пути заражения
Как выглядит клещ – демодекс
Некоторые ученые уверяют, что клещ Demodex – неотъемлемая составляющая нормальной флоры живого существа. То есть клещ живет на коже собаки, однако не каждый раз вызывает такую сложную и опасную болезнь.
Существует мнение, что демодекоз передается от матери к щенку, то есть передается по наследству. Согласно исследованиям другой группы ученых, демодексы не такие уж доброжелательные «соседи» для собак. И у восьми процентов собак клещ есть, следовательно, источники заражения – другие болеющие собаки.
Таким образом, говорим о двух точках зрения о путях заражения домашних собак:
- Первая – контакты с зараженным животным опасны и приводят к демодекозу.
- Вторая – животное заболеет и без контакта с носителем подкожного клеща, при условии резкого и сильного снижения иммунитета.
Формы и симптомы демодекоза
Подбор правильного лечения важен. Для установки необходимого курса медикаментов ветеринары для начала определяют форму болезни.
Первая форма – очаговая (локальная). Это легкая и безвредная степень. Болезнь протекает следующим образом – появляются шелушащиеся участки кожи. Располагаются без порядка. И количество достигает в среднем от трех до пяти. В том случае если домашний питомец не ощущает сильных недомоганий, возможно самолечение. Однако это может привести к последующим ухудшениям самочувствия собаки. Поэтому рекомендуем все же обратиться в ветеринарную клинику.
Локальная форма демодекоза у собаки
Генерализованный демодекоз – это еще одна разновидность болезни. От очаговой отличается большей силой повреждения кожи собаки. Помимо кожных покровов, поражены и внутренние органы. Шелушащиеся безволосые участки в количестве превышают пять штук, границы постоянно расширяются, а кожа приобретает крайне неприятный запах. Эта форма демодекоза без грамотного лечения приведет к смерти собаки, так как сильному повреждению подвергается иммунитет животного.
Генерализованная форма
И последняя третья форма заболевания называется ювенильной. Присуща больше для щенков возрастом до одного года. В этом случае можно говорить о наследственной предрасположенности собаки к заражению подкожным клещом. Тогда ветеринары рекомендуют провести лечение не только щенка, но и матери.
Виды заболевания и симптомы
По количеству поражений кожи различают 3 вида заболевания:
- Бессимптомный демодекоз. Протекает скрытно. Чтобы выявить хоть один симптом, нужен тщательный осмотр питомца.
- Локализованный (очаговый). Преимущественно на голове и в области глаз, на передних конечностях появляются до 5 зон облысения, 2-5 см в диаметре. Может наблюдаться зуд.
- Генерализованный (общий). Увеличивается количество алопеций по всему телу, добавляются новые симптомы. Поражаются также и внутренние органы. Пятна сливаются, образуя обширные участки. Появляется зуд и признаки интоксикации: слабость, рвота, понос, нарушение координации движений. Эта форма может быть продолжением очаговой либо развивается сразу.
Обратите внимание!
5 зон залысин для ньюфаундленда считаются еще очаговой формой, а для чихуахуа и 3 пятна – уже генерализованный демодекс.
В зависимости от симптомов, различают следующие формы железницы:
- Чешуйчатая (сквамозная). Первый симптом – появление на теле безволосых участков. Кожа в этих местах уплотняется, покрывается чешуйками, растрескивается. Цвет меняется от розового до серовато-голубого.
- Папулезная. Характерный симптом – красные узелки размером до полусантиметра. Эта форма, как и чешуйчатая, животное не беспокоит и характерна для локализованного демодекоза.
- Пустулезная (пиодемодекоз). На опухшей коже появляются высыпания, которые заполняются гноем. По мере созревания пустулы лопаются, и на их месте образуются струпья. По отзывам ветеринаров, часто присоединяется микробная инфекция – тогда образуются нарывы и язвы. Дополнительный симптом – хромота.
- Смешанная. Наблюдаются все вышеназванные симптомы. Протекает заболевание тяжело. Собака в угнетенном состоянии, теряет аппетит и подвижность.
2 последние в списке формы заболевания обычно наблюдаются при генерализованной железнице.
Возможно ли полное излечение от демодекоза
Терапия паразитарного заболевания, напрямую зависит от породной принадлежности животного, его веса и запущенности течения. Разработка тактики лечения должна проводиться только специалистом, так как различные лекарственные средства обладают своей степенью токсичности.
Локальная форма ювенильного демодекоза, не требует особого лечения, но важно проведение постоянного контроля за состоянием. Причина – возможный переход в генерализованную форму, лечение которой требует особого подхода, длительностью от 1.5 месяцев до полугода
Полное излечение от демодекоза возможно. Полностью здоровой собака считается после двух негативных соскобов, проведенных с интервалом в 1 месяц. Самостоятельно назначать препараты и проводить лечение, не рекомендуется в связи с возможными рисками развития осложнений.
Полностью здоровым питомец считается только тогда, когда в течение 12 месяцев рецидивов демодекоза не наблюдалось. При этом, собаку необходимо каждые 6 месяцев показывать ветеринарному врачу.
Исследование на демодекоз у собак, соскоб: где проводить?
При проявлении вышеперечисленных признаков собаку необходимо срочно везти к специалисту в хорошую проверенную ветеринарную клинику. Прежде, чем проводить какое-либо лечение, необходимо выявить возбудителя. Ведь даже в том случае, если симптомы недуга питомца совпадают с признаками демодекоза, причина заболевания может крыться в чем-то другом.
Специалист должен назначить бакпосев. Этот анализ позволит с высокой степенью точности определить вид микроба и, как следствие, его реакцию на антибиотики.
Также важно учесть текущее состояние животного, ведь не исключено, что у него могут иметься заболевания. Сделать это может только специалист, потому домашнее лечение на основе советов знакомых исключено
Для того, чтобы избавиться от демодекоза, у собаки должен обязательно браться анализ для лабораторного исследования
Симптомы демодекоза
Первыми симптомами демодекоза у собак, как правило, являются участки выпавшей шерсти – алопеции – чаще всего, в области морды, головы, пальцев (лап). Обычно зуд у собаки не наблюдается, особенно на начальной стадии болезни, и может проявляться только при вторичной бактериальной инфекции (поврежденные участки кожи – хорошая среда для патологического размножения бактериальной флоры). Пиодерма (бактериальное воспаление кожи) – частая проблема при демодекозе, осложняющая его течение.
При тяжелых случаях генерализованного демодекоза симптомы более выражены, собака может быть практически полностью лысой, кожа быть со струпьями и неприятным запахом из-за вторичной бактериальной или грибковой инфекции. Общее состояние при этом ухудшается, может наблюдаться отказ собаки от еды, снижение активности, сильный зуд.
Формы и симптомы демодекоза у животных
Локализованный демодекоз. Отмечается появление 3-5 алопеций с небольшим покраснением и шелушением на голове, в области морды и вокруг глаз, частично на ногах. Зуд бывает редко. Может наступать спонтанное выздоровление через 1-2 месяца.
Генерализованный демодекоз. Возникает, если начало развития локализованного демодекоза не было вовремя распознано, и далее заболевание осложнилось иммуносупрессией различной этиологии (например, терапия глюкокортикоидами), также у ослабленных молодых или пожилых собак. При этом описанные выше повреждения начинают распространяться по всему телу, дополнительно развивается фолликулит, присоединяется бактериальная инфекция, которая проникает глубоко в кожу, вызывая вторично пиодермию. Может наблюдаться увеличение региональных лимфоузлов, ухудшение общего состояния. Развитие генерализованного демодекоза часто начинается в 3-18 месячном возрасте.
Выделяют также ювенильный демодекоз у щенков с ослабленной иммунной системой. Таких щенков в будущем нельзя использовать для разведения.
Пододемодекоз – поражение одной или нескольких конечностей. Может иметь место как остаточное явление после генерализованного заболевания или как единственная зона поражения, при этом также часто присоединяется пиодермия, которая приводит к развитию воспалительного отека.
Отодемодекоз – поражение наружного слухового прохода с развитием отита.

Возможные осложнения
Осложнений при локализованной форме течения демодекоза и своевременном лечении, как правило, не отмечается. К основным возможным осложнениям можно отнести вторичное инфицирование бактериальными и грибковыми агентами. При несвоевременном лечении также будет отмечаться увеличение пальпируемых лимфоузлов, повышение температуры тела, общее угнетение, отказ от еды, нестерпимый зуд. Далее возникает сепсис и гибель животного.
Скорее выбирай коробку и узнай, какой подарок тебя ждет
Скидка на страховку для питомца
Промокод скопирован в буфер
Статья не является призывом к действию!
Для более детальной проработки проблемы рекомендуем обратиться к специалисту.
Спросить ветеринара
Статья была полезна?
Спасибо, давайте дружить!
Подписывайтесь на наш Инстаграмм
Подписаться
Спасибо за обратную связь!
Давайте дружить — скачайте приложение Petstory
2 сентября 2020
Обновлена: 13 февраля 2021
7 полезных свойств дегтярного мыла
Дегтярное мыло снимает излишки жира, выделяемого сальными железами, уменьшает потливость, предотвращая закупорку пор с последующим образованием воспаления, и подсушивает кожу. Благодаря этому она становится гладкой и менее подвержена возникновению черных точек и прыщей.
Деготь стимулирует кровообращение кожи головы, обеспечивая достаточное поступление кислорода и питательных веществ. Этим дегтярное мыло приносит огромную пользу для волос: оно способствует исчезновению перхоти, волосы меньше выпадают, становятся более густыми и блестящими. Использование мыла также снижает активность сальных желез, благодаря чему они дольше не засаливаются и выглядят ухоженными.
Совместное действие эфирных масел и дубильных веществ оказывает противовоспалительный и вяжущий эффект, останавливая размножение и деятельность бактерий. Это свойство дегтярного мыла полезно не только для лечения кожи лица, но и при воспалениях слизистых оболочек.
Деготь снимает воспаления, очищая поврежденные ткани и предотвращая появление гнойников. Одновременно он стимулирует их регенерацию и ороговение. Это полезно для кожи тела: наружные покровы становятся менее уязвимыми для повреждений.
Дегтярное мыло применяют для выведения и профилактики вшей, а также блох у домашних животных.Дёготь оказывает отравляющее воздействие на насекомых благодаря содержанию щелочи, фенола и крезола. Эти вещества вызывают у паразитов химические ожоги, создавая неблагоприятную для жизни среду.
Химический состав дегтя пагубно влияет на грибок, подавляя его рост. Он восстанавливает поврежденные ткани и устраняет шелушение. Дегтярное мыло в виде раствора можно использовать для лечения грибковых заболеваний садовых и домашних растений.
Улучшает кровоснабжение кожных покровов
Содержащиеся в дёгте катехины, лейкоантоцианы и фенол укрепляют стенки сосудов, стимулируя кровообращение наружных покровов. Это обеспечивает поступление кислорода и питательных веществ, ускоряет процессы роста и заживления, снимает болезненность.
Демодекоз век
Лечение демодекоза век нуждается в комплексом подходе и квалифицированном медицинском вмешательстве. Демодекозный блефарит является хронической болезнью, которая протекает с периодическим обострением и ремиссией. Он отличается следующей клинической картиной:
- Сильная усталость глаз, связанная с необходимостью напрягаться для лучшей фокусировки на предмете или буквах;
- Интенсивный зуд в области ресниц и бровей. Нередко этот симптом усиливается при внешнем воздействии тепла, в вечернее и ночное время суток;
- Ощущение инородного тела, жжение и пощипывание, не устраняющееся после промывания или чесания;
- Вязкие выделения из глаз после пробуждения;
- Накопление пенистого содержимого в глазных уголках;
- Гиперемия, отечность и утолщение век (особенно по краям).
- Хроническая форма демодекозного блефарита может осложниться кератоконъюктивитом, кератитом и синдрома сухого глаза. Поэтому настоятельно рекомендуется проконсультироваться с офтальмологом нашей клиники, который сможет назначить профилактическую и лечебную терапию, направленную на сохранение глазного здоровья.
О клеще Demodex

Клещи Demodex считаются условно-патогенными. Это означает, что они могут обитать и на коже здорового человека, – их присутствие не всегда приводит к развитию заболевания. Разные исследования указывают разную распространённость Demodex. Во всяком случае, носителями этих клещей является не менее 50% людей; некоторые исследователи называют цифру 97%. Считается, что среди детей и лиц молодого возраста носителей клещей Demodex меньше, с возрастом количество носителей возрастает, и пожилые люди практически все поражены этим клещом.
Demodex обитает в сальных железах и волосяных фолликулах, предпочитая лицо остальным частям тела. Более крупные клещи – Demodex folliculorum чаще всего выбирают волосяные фолликулы ресниц и бровей. Demodex brevis предпочитает селиться в сальных железах крыльев носа, носогубных складок, подбородка. Однако клещи могут встречаться и на других участках кожи, в том числе – на щёках, шее, груди и спины.
Клещ Demodex не виден невооруженным глазом. Особь Demodex folliculorum может достигать размера 0,5 мм; Demodex brevis еще меньше – не более 0,15 мм. Demodex не любит света и наиболее активен в ночное время. Самая комфортная для него температура – 30-40 °C , поэтому клещ активизируется в весенне-летний период.
Чем опасен подкожный клещ для собак?
Генерализованный демодекоз является опасным кожным заболеванием, которое может закончиться даже смертельным исходом в связи с истощением, интоксикацией и вторичными бактериальными инфекциями.
Тем не менее, однажды столкнувшись с данной проблемой, владельцы собак и заводчики зачастую думают, что они знают как вывести подкожного клеща у собаки. Действительно, можно воспользоваться поиском в Интернете по запросу «демодекоз у собак лечение препараты» или «демодекоз у собак схема лечения» и найти способ как вылечить демодекоз у собаки. Однако, демодекоз возникает в результате воздействия ряда факторов, которые приводят к снижению иммунитета и позволяют клещу, в норме присутствующему в коже в небольшом количестве, активно размножаться, что способствует воспалению кожи и развитию вторичных бактериальных инфекций. Продукты жизнедеятельности множества клещей попадают в кровь собаки, что может привести к нарушению функции внутренних органов и истощению. Кроме того, причиной развития демодекоза у взрослых и пожилых собак могут быть серьезные болезни, например болезнь Кушинга, сахарный диабет или рак, потеря времени без лечения в этих случаях может быть фатальной.
Диагностика демодекоза
Для постановки диагноза требуется взятие глубоких соскобов кожи (до появления крови) минимум из 5 мест поражений на собаке. Так как клещи (если их количество мало) в соскобах обнаруживаются не всегда, то отрицательный результат еще не свидетельствует об отсутствии демодекоза.
Демодекоз является далеко не единственным дерматологическим заболеванием у собаки, сопровождающимся выпадением шерсти. Эти симптомы (особенно в сочетании с зудом) могут быть признаками множества других патологий, в том числе и являющихся заразными для других питомцев или для человека. Поэтому при проявлении симптомов зуда (собака испытывает беспокойство, разлизывает себя) в любом случае необходим прием врача-дерматолога для определения причины его возникновения.
Паразитология
Клещи Demodex canis – часть нормальной фауны кожи, они присутствуют в коже и наружных слуховых проходах у многих здоровых собак, не вызывая заболевания. Однако при снижении иммунитета эти микроскопические клещи начинают размножаться в волосяных луковицах и их придатках, что приводит к поражению кожи и потере шерсти. Эти паразиты могут обитать только в коже, однако при исследовании тканей собак, погибших в результате болезни, их обнаруживали и во внутренних органах, а также в моче, крови и фекалиях. Тем не менее, это стоит считать случайными находками, поскольку демодекс дышит кислородом и не может жить без доступа воздуха во внутренних органах. Обнаружение клещей вне кожи связано с заносом мертвых клещей из очага воспаления с кровью или лимфой.
Весь жизненный цикл демодекса проходит только в коже животного, включает яйца, личинки, нимфы и взрослых паразитов. Попадая в окружающую среду, клещи быстро погибают, выживая не более часа при комнатной температуре. В лабораторных условиях эти клещи выживали до месяца, однако заразить ими собак не удавалось.
Как выглядит подкожный клещ у собак можно увидеть только на фото с микроскопа, поскольку размер клещей не позволяет увидеть их невооруженным глазом и составляет менее 0,3 миллиметра.
Фото. Клещ Demоdex canis при увеличении микроскопа в 400 раз








![Демодекоз у собак [симптомы, причины, лечение, препараты]](https://ferret-pet.ru/wp-content/uploads/e/1/5/e15de48c01f8383dc0e2429f99180610.jpeg)


























